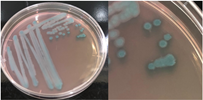

INTRODUCCIÓN
Los ecosistemas de manglar se distribuyen por las costas tropicales y subtropicales (Carvajal-Oses et al., 2019). Este entorno se encuentra expuesto a continuos cambios causado por diferentes factores como: la disponibilidad de nutrientes, temperatura del agua, salinidad y niveles de oxígeno, lo que convierte a este tipo de ecosistemas en únicos al albergar una gran biodiversidad de microor-ganismos (Baskaran et al., 2023). Así mismo, destacan por presentar una alta productividad primaria, resultado de la actividad microbiana realizada por hongos, bacterias y arqueas, siendo estos organismos necesarios para mantener en buen funcionamiento los ecosistemas de manglar (García-Martínez et al., 2021).
El género Bacillus es predominante en los ecosis-temas de manglar, se encuentra especialmente asociado con Rhizophora mangle y Avicennia nítida (Castro et al., 2014). Estas bacterias, son Gram positivas, catalasa positiva, formadoras de esporas, con forma de bastón, aeróbicas o anaerobias facultativas, se encuentran comúnmente en suelos ácidos, salino-alcalinos o suelos desérticos (Alyousif, 2022; Soltani et al., 2019).
Estas bacterias desempeñan múltiples funciones ecológicas, incluyendo el control biológico me-diante la producción de metabolitos y enzimas líticas, el reciclaje de nutrientes y la producción de ácidos orgánicos y antibióticos (Dame et al., 2021; Rojas-Badía et al., 2020).
El uso de medios cromogenicos permite la iden-tificación y aislamiento de microorganismos específicos al producir colonias con formas y colores distintivos, facilitando la identificación rápida y reduciendo la necesidad de pruebas adicionales (Shaban et al., 2024). Estos medios utilizan sustratos cromogénicos (X-Gal o X-Glu, ONPG), los cuales, al ser metabolizados por micro-organismos con sistemas enzimáticos específicos, liberan un colorante que se fija a las colonias microbianas, permitiendo su diferenciación (Granja et al., 2021; Leena Sankari et al., 2019).
A pesar de la alta diversidad microbiana en los manglares, la información sobre la variedad de bacterias Bacillus en estos ambientes es limitada. El objetivo de este estudio es llenar este vacío al proporcionar información sobre la identificación y caracterización de estas bacterias utilizando un medio cromogénico especializado. Al hacerlo, buscamos profundizar en la comprensión de su rol en estos ecosistemas y facilitar futuras investigaciones en este campo.
METODOLOGÍA
Área de estudio
El estudio se lo llevo a cabo en el manglar de la zona de Puerto Hualtaco, Huaquillas, El Oro, Ecuador. Las muestras de sedimento se recolectaron en tres sitios diferentes: Punto 1 (3°26'52.91"S, 80°13'24.86"W), Punto 2 (3°26'29.39"S, 80°13'4.66"W) y Punto 3 (3°25'22.08"S, 80°14'54.74"W).
Muestreo
Las muestras se recolectaron en la mañana, cuando la marea comenzaba a subir con temperatura ambiental de 24 °C. Para la recolección, se utilizó la técnica de puntos sospechosos (Thomas et al., 2020). Las muestras se extrajeron a una profundidad de 10 cm del sedimento con una cuchara de jardín y se colocaron en bolsas ziploc. Luego, se almacenaron en una nevera corcho a 10 °C para su mantenimiento. Posteriormente, las muestras se trasladaron al Laboratorio de microbiología, Facultad de Ciencias Agropecuarias, Universidad Técnica de Machala.
Siembra y Aislamiento
Se empleo la metodología reportada por Harwood (1989) y Yilmaz et al. (2006). Para ello, se tomó 1 g de sedimento de cada muestra, se la coloco en 9 ml de solución salina al 1.5 % y se homogenizo por 2 minutos. Después, las muestras fueron calentadas a 80 °C en baño maría durante 10 minutos, seguido se realizó diluciones seriadas desde 101 hasta 107 y se sembró 100 μl en placas con agar cromogénico (HiCromeTM Bacillus Agar Base), preparado según las indicaciones del fabricante (49 g/L) y esterilizado en autoclave (Modelo ALL-75X-120V) a 120 PSI durante 15 minutos. Las placas fueron colocadas en la incubadora (Incucell IC55 Eco) a 30 °C durante 24 a 48 h.
Para el aislamiento, se utilizó la técnica de estría cruzada para obtener colonias individuales y puras (Sánchez et al., 2017). Este medio selectivo facilita la identificación de colonias, lo que permite aislarlas de manera efectiva según su coloración. Además, se realizó tinción de Gram y de Schaeffer-Fulton para confirmar que las cepas aisladas son Gram positivas y producen esporas, características propias del género Bacillus (Jurado et al., 2021).
Caracterización morfológica
Se realizo una caracterización macro y micros-cópica de las bacterias siguiendo el protocolo descrito por Jackman (2012). Para la caracteri-zación macroscópica, se describieron las colonias en términos de su forma, altura, margen, apariencia de la superficie y color. En cuanto a la carac-terización microscópica, se hizo tinción de Gram y de esporas. Posteriormente, se observó al micros-copio (Euromex trinocular BSCOPE BS.1153-EPLI) y se utilizó un objetivo de 100x con aceite de inmersión. La imagen fue capturada mediante un sistema de cámara conectada al microscopio para registrar su característica externa y medir su tamaño.
Pruebas bioquímicas
Se realizaron diversas pruebas bioquímicas, entre ellas la prueba de la catalasa. En esta prueba, se colocaron dos gotas de peróxido de hidrogeno al 30% sobre un portaobjetos. Con un asa bacte-riológica, se tomó una muestra de una colonia pura y se la añadió al peróxido. La producción de burbujas indica una reacción catalasa positiva, mientras que la ausencia una reacción negativa (Ali et al., 2020).
Se realizó el test de hidrólisis de gelatina utilizando una metodología propia. Para preparar el medio, se disolvieron 10 g de gelatina sin sabor (14% de proteína), 1 g de peptona (marca BactoTM) y 1 g de NaCl en 100 ml de agua destilada. La mezcla se esterilizó en autoclave a 120 PSI durante 15 minutos. Posteriormente, se distribuyeron 8 ml del medio en tubos de ensayo de 10 ml y se inoculó la bacteria utilizando un asa bacteriológica. Los tubos se incubaron a 30 °C durante 4 días. Luego, se refrigeraron durante 2 horas. La presencia de solidificación del medio indica que no se produjo hidrólisis de la gelatina, mientras que la ausencia de solidificación sugiere que la hidrólisis ha ocurrido.
Finalmente, se realizó la prueba de motilidad utilizando una metodología adaptada. Se prepararon 2,5 g de peptona de soya (marca HIMEDIA) y 0,4 g de agar en 100 ml de agua destilada y 1% NaCl. El medio fue esterilizado en autoclave a 120 PSI durante 15 minutos. Después de la esterilización, el medio se distribuyó en tubos de ensayo con 10 ml cada uno. Usando un asa bacteriológica con punta de aguja, se tomó una muestra de la bacteria y se inoculó de manera lineal en el medio de cultivo. Los tubos se incubaron durante 24 horas a 30 °C, luego de este tiempo se evaluó la motilidad. Si el medio presenta turbidez o crecimiento fuera de la línea de inoculación, el resultado se considera positivo, indicando la presencia de motilidad en la bacteria. Además, en esta prueba de motilidad también se evaluó la capacidad de formación de Biofilm (biopelícula), observando que el biofilm se manifestaba como una capa blanquecina en la parte superior adherida a las paredes del tubo.
Pruebas fisiológicas
Crecimiento a diferentes niveles de salinidad (0 y 7%): Para preparar el medio con 0% de salinidad, se utilizaron 2 g de agar y 1,5 g de peptona, mezclados con 100 ml de agua destilada en un matraz. Para el medio con 7% de salinidad, se emplearon 4,9 g de agar cromogénico y 6 g de NaCl (ya que el medio cromogénico contiene 1% de NaCl). Estos componentes se disolvieron en 100 ml de agua destilada. Después de preparar ambos medios, se esterilizaron en autoclave a 120 PSI durante 15 minutos. Tras la esterilización, los medios se vertieron en placas y se sembraron las bacterias por estrías. Las placas se incubaron a 30 °C durante 24 horas, luego se observó la presencia o ausencia de crecimiento.
Crecimiento a diferentes niveles de pH (6, 8 y 9): Para preparar el medio con un pH de 8 y 9 se utilizaron 4,9 g de agar cromogénico disueltos en 100 ml de agua destilada. Se midió el pH de la solución con un multiparámetro (Tri meter 3 en 1) y se ajustó el pH añadiendo bicarbonato de sodio hasta alcanzar los valores deseados. El mismo procedimiento se empleó para ajustar el medio a un pH de 9. Para preparar el medio con un pH de 6, se utilizó Soya Peptona (marca HIMEDIA), mezclando 2 g del medio en 100 ml de agua destilada y ajustando el pH con ácido clorhídrico al 1 % y la ayuda del multiparámetro hasta alcanzar el valor deseado. Una vez preparado los medios con los diferentes pH, se esterilizaron en autoclave a 120 PSI durante 15 minutos. Luego, el medio con pH 8 y 9 se vertió en placas, mientras que el medio con pH 6 se lo distribuyo en tubos de ensayo de 10 ml, Las bacterias se sembraron en los diferentes medios y se incubaron a 30 °C durante 24 horas. Finalmente, se observó la presencia o ausencia de crecimiento.
Inhibición de Vibrio spp.
Para esta prueba de sensibilidad se utilizó agar Mueller Hinton (Marca Scharlau). Se pesaron 3,9 g del agar, 1% NaCl y se disolvió en 100 ml de agua destilada. La mezcla se esterilizo en autoclave a 120 PSI durante 15 minutos y luego se colocó en placas petri. Para ver el efecto inhibitorio se empleó cepas de Vibrios totales aislados previamente de camarones con una concentración 108 UFC/ml (0.5 Macfarland). Se usó una varilla digrasky estéril para extender la bacteria por toda la superficie de la placa. Luego con un asa bacteriológica estéril, se tomó cada cepa de Bacillus y se colocaron sobre la placa previamente inoculada con el patógeno y se incubaron a 30 °C durante 48 horas, para observar la formación de halos de inhibición.
RESULTADOS Y DISCUSIÓN
En este estudio, se aislaron un total de ocho cepas bacterianas del ecosistema de manglar, identifi-cadas mediante caracterización morfológicas y crecimiento en el medio cromogénico. Este medio de cultivo permitió observar características distin-tivas en la morfología de las colonias y coloración, lo que facilitó identificar a las bacterias. Las pruebas complementarias permitieron una evalua-ción exhaustiva de las bacterias, abarcando su actividad metabólica, capacidad de esporulación, y respuesta a diversas condiciones ambientales, entre otros aspectos relevantes.
Características morfológicas de las colonias de Bacillus aisladas
La Tabla 1 presenta figuras del crecimiento de las distintas cepas de Bacillus en placas de agar cromogénico. Además, detalla las características morfológicas de las colonias, facilitando su identificación y diferenciación, y proporciona una base sólida para comprender sus rasgos distintivos.
La Tabla 1, fila a, presenta la cepa identificada como B. thuringiensis (Bt), la cual guarda una estrecha relación con B. cereus y B. mycoides (El-Arabi & Griffiths, 2021), lo que puede generar confusión en su identificación en medios cromogenicos. Sin embargo, B. thuringiensis se distingue por presentar bordes irregulares, a diferencia de B. cereus, que exhibe bordes redondeados bien definidos, según lo descrito en el manual del producto. Las características macroscópicas observadas en la Tabla 1, fila a, coinciden con las descritas en dicho manual. Además, la apariencia de las colonias es similar a la cepa aislada por Bahuguna et al. (2020), quienes emplearon el mismo medio cromogénico utilizado en este estudio y confirmaron la identidad de la cepa mediante análisis de 16S rRNA, RAPD-PCR, PCR específica para B. thuringiensis y tinción de proteínas cristalinas. Así mismo, Roy et al. (2022) aislaron esta cepa utilizando un medio cromogénico y confirmo su identidad por PCR multiplex como B. thuringiensis.
La Tabla 1, fila b, presenta la cepa identificada como B. coagulans (Bc), cuyas características macroscópicas coinciden con las descritas en el manual del medio cromogénico utilizado y en los estudios de Alippi & Abrahamovich (2019). Además, la figura de la fila b refleja la apariencia del aislado en medio cromogénico de la misma cepa, obtenida en trabajos previos de Roy et al. (2022) y Alippi (2019), quienes confirmaron la identidad de la cepa mediante secuenciación de 16S rRNA.
La Tabla 1, fila c, presenta la cepa identificada como B. megaterium (Bm), cuya apariencia es similar a la de los aislados en placa con medio cromogénico reportados por Roy et al. (2022) y Alippi (2019), quienes confirmaron su identidad mediante secuenciación de 16S rRNA. Las características macroscópicas de esta cepa coinciden con las descritas en el manual del medio cromogénico y con las observadas por Alippi & Abrahamovich (2019). En cuanto a las características microscópicas, las mediciones del tamaño bacteriano obtenidas en nuestro estudio coinciden con las de Sura & Hiremath (2019).
La Tabla 1, fila d, presenta la cepa identificada como B. cereus (Bce), cuyas características coinciden con las descritas en el manual del producto cromogénico y con las reportadas por Alippi & Abrahamovich (2019) y Constanza et al. (2014). Además, la apariencia de las colonias mostradas en esta fila coincide con la del aislado en placa realizado por Alippi (2019), quien confirmo la identidad de esta bacteria mediante secuenciación 16S rRNA.
La Tabla 1, fila e, presenta la cepa identificada como B. velenzensis (Bv), cuya apariencia coincide con la reportada por Bahuguna et al. (2020), quienes aislaron esta cepa utilizando el mismo medio cromogénico que se empleó en nuestro estudio. Las características observadas por Bahuguna et al. (2020), Devi et al. (2019) y Ruiz-García et al. (2005), como colonias de color blanco, irregulares con forma arrugada, coinciden con las reportadas en nuestro trabajo. Bahuguna et al. (2020) confirmaron la identidad de esta cepa mediante secuenciación 16S rRNA, consolidando su identificación como B. velezensis.
La Tabla 1, fila f, presenta la cepa identificada como B. lincheniformis (Bl), cuyas características coindicen con las descritas por Alippi & Abrahamovich (2019) y Bahuguna et al. (2020). Estos autores aislaron esta bacteria utilizando medio cromogénico, la caracterizaron y confirmaron su identidad mediante secuenciación 16s rRNA. Las características observadas en nuestro estudio, junto con la pigmentación amarilla del medio, coinciden con las reportadas por estos autores. En cuanto a la apariencia, esta cepa comparte similitudes con el aislado cultivado en medio cromogénico por Bahuguna et al. (2020). La Tabla 1, fila g, presenta la cepa identificada como B. mycoides (Bmy), la cual no ha sido previamente caracterizada en estudios que utilicen medio cromogénico ni descrita en el manual del producto. Sin embargo, al inocular la cepa en otro tipo de medio, se pudo identificar como B. mycoides debido a la forma rizoide de las colonias (Fig. 2), una característica común en esta cepa (Órdenes-Aenishanslins et al., 2014). Además, la coloración azulada observada en la cepa (figura de la Tabla 1, fila g) podría atribuirse a su estrecha relación con el grupo B. cereus (El-Arabi & Griffiths, 2021; Kumari & Sarkar, 2016).
Tabla 1 Representación visual y características de las colonias de Bacillus aisladas
Nota: a): Bacillus thuringiensis, b): Bacillus coagulans, c): Bacillus megaterium, d): Bacillus cereus, e): Bacillus velezensis, f): Bacillus licheniformis, g): Bacillus mycoides y h): Bacillus amyloliquefaciens.
La Tabla 1, fila h, presenta la cepa identificada como B. amyloliquefaciens (Ba), cuyas características y apariencia coinciden con las reportadas en los estudios de Alippi (2019) y Alippi & Abrahamovich (2019). En ambos estudios, se realizó análisis de secuenciación 16S rRNA para confirmar la identificación de la cepa.
Resultados de las pruebas realizadas
Todas las cepas son Gram positiva, presentaron esporas, fueron catalasa positiva, hidrolizan gelatina, son móviles, forman biofilm y crecen a pH 6 y 8. No obstante, solo Bt, Bc, Bv y Ba lograron crecer a pH 9. En cuanto a la salinidad, todas las cepas crecieron al 0% de salinidad, mientras que Bm, Bce, Bv, Bl y Ba lograron crecer al 7%. Respecto a la prueba de inhibición de Vibrio solo las cepas Bv, Bl y Ba mostraron capacidad para inhibir su crecimiento.
Los resultados obtenidos para Bacillus thuringiensis (Bt) coinciden con los hallazgos de Romero et al. (2017). Se confirma que esta bacteria es Gram positiva, con capacidad para formar esporas ovaladas, cada una asociada con un cristal paraesporal. Además, presenta una reacción positiva en las pruebas de hidrólisis de gelatina y catalasa. Los resultados de la prueba de motilidad son consistentes con los reportados en Rodríguez (2011), dado que el microorganismo creció más allá del área de punción. En cuanto al crecimiento en diferentes valores de pH, nuestra cepa mostró un crecimiento adecuado en pH 6, 8 y 9. Estos hallazgos concuerdan parcialmente con los repor-tados por Carrera (2010), observando crecimiento en un rango de pH de 5,5-8,5, con pH óptimo entre 6,5 y 7,5. Respecto al crecimiento en diferentes concentraciones de NaCl, nuestra bacteria mostró crecimiento positivo en 0% de NaCl, pero no en 7%. Estos resultados coinciden parcialmente con lo reportado por Rodríguez (2011), quien observó crecimiento en concentraciones de hasta 5% de NaCl, pero no en 7%. Romero et al. (2017) también reporta crecimiento en concentraciones de 1% y 5% de NaCl, lo que refuerza la idea de que concentraciones superiores a 5% pueden inhibir el crecimiento. Asimismo, nuestra cepa presentó actividad de formación de biopelículas. Este hallazgo coincide con lo reportado por Zhao et al. (2024), quien señala que B. thuringiensis tiene la capacidad de formar biopelículas. En relación con la capacidad de inhibir Vibrio spp., nuestros hallazgos difieren de los reportados en Masitoh et al. (2016), que indican un alto potencial antibacteriano contra este patógeno. Esta discrepancia podría atribuirse a las variaciones en las cepas de Vibrio spp. utilizadas en los métodos de ensayo. En nuestro estudio se empleó Vibrios totales mientras que en el estudio de referencia se utilizó Vibrio harveyi.
Los resultados de Bacillus coagulans (Bc) concuerdan con la literatura en varios aspectos, como su carácter Gram positivo, la capacidad de formar esporas, la catalasa y la motilidad positivas, y la capacidad de hidrolizar gelatina, lo cual está en línea con los estudios de Zhou et al. (2020), Yanting et al. (2022), Carrera (2023) y Uono (2019). Además, B. coagulans mostró crecimiento con pH de 6, 8 y 9, lo que sugiere una amplia tolerancia al pH, capaz de crecer en ambientes ligeramente ácidos y alcalinos. Estos resultados coinciden con los hallazgos de Yanting et al. (2022), quienes reportaron crecimiento en condiciones de pH tan bajo como 3, y con Medda & Chandra (1980), quienes observaron un crecimiento óptimo en pH 8,5 aunque con una disminución de actividad en pH 9. Además, se observó crecimiento a NaCl 0%, pero no a 7%, lo que coincide con Medda & Chandra (1980), aunque difiere de Uono (2019), quien reportó crecimiento en medios con hasta 6,5% de NaCl. Por otro lado, nuestra cepa mostró formación de biofilm, pero no presentó actividad antimicrobiana contra Vibrios. Esto difiere parcialmente de lo reportado por Konuray & Erginkaya (2021), quienes describen la formación de biofilm y la actividad antimicrobiana en B. coagulans, aunque sin especificar su efectividad contra bacterias del género Vibrio. Además, no se han realizado estudios previos que evalúen su actividad antimicrobiana contra este género. Estas variaciones podrían reflejar la diversidad genotípica de B. coagulans.
Los resultados obtenidos en este estudio para Bacillus megaterium (Bm) muestran una concor-dancia general con los reportados por Sura & Hiremath (2019) y Sosa et al. (2011). Coincidimos en que la bacteria es Gram positiva y presenta esporas. La actividad catalasa fue positiva en ambos estudios, lo que refuerza la identidad de la cepa. La hidrólisis de gelatina fue parcial, ya que la cepa logró hidrolizar solo una parte de la gelatina, dejando el resto sin hidrolizar; esto podría haber sucedido debido a que la cepa presenta una capacidad enzimática lenta para hidrolizar la gelatina. El crecimiento en concentraciones de NaCl al 7% fue consistente tanto en nuestro estudio como en el de Sosa et al. (2011). En cuanto a la motilidad, obtuvimos resultados positivos que son similares a los reportados por Sura & Hiremath (2019). También se obtuvo presencia de Biofilm, lo cual coincide con Komunikasi et al. (2021). Por último, la cepa Bacillus megaterium no mostró una capacidad inhibitoria significativa contra Vibrios. Sin embargo, Viet Cuong et al. (2014) reportó que B. megaterium si exhiben actividad antimicrobiana contra este patógeno. Esta discrepancia podría deberse a la variabilidad genética entre las cepas, que puede influir en la producción de metabolitos antimicrobianos.
Los resultados obtenidos para Bacillus cereus (Bce) corroboran los datos reportados por Pérez (2012), confirmando que se trata de un bacilo Gram positivo, formador de esporas, con motilidad y catalasa positivas, con capacidad para hidrolizar gelatina. Estos hallazgos son consistentes con la caracterización observada en este estudio. En cuanto al rango de pH, B. cereus exhibe un crecimiento óptimo en pH de 6 y 8, pero no en 9, lo cual concuerda parcialmente con los datos repor-tados por King et al. (2007), quienes indicaron que crecen en un rango de pH de 5 a 8,8.
Respecto a la tolerancia a NaCl, la cepa mostró un crecimiento óptimo en condiciones de 0 y 7% NaCl. Este resultado es consistente con los datos de Portales (2020), quienes también encontraron que B. cereus crece adecuadamente en ausencia de sal, pero presenta una tolerancia limitada a concentra-ciones superiores al 7% NaCl. En cuanto a la formación de biofilm, nuestra cepa mostró capacidad para formar biofilm, lo que coincide con los hallazgos de Wijman et al. (2007), quienes reportaron que B. cereus puede formar biofilms. Y con respecto a la capacidad de la cepa para inhibir Vibrios, estos resultados difieren de los reportados por Masitoh et al. (2016), que señala que la cepa posee un potencial antibacteriano significativo contra bacterias de este género. Las diferencias observadas podrían atribuirse al uso de distintas cepas de Vibrio spp. en nuestro estudio. En el trabajo referenciado se empleó Vibrio harveyi, mientras que en el presente estudio se utilizó Vibrios totales.
Los resultados obtenidos para Bacillus velezensis (Bv) son coherentes con estudios previos, ya que la cepa mostró ser Gram positiva, catalasa positiva, formadora de esporas, motilidad positiva y capaz de hidrolizar gelatina (Ruiz-García et al., 2005). Además, presentó crecimiento a concentraciones de NaCl de 0% y 7%, así como valores de pH 6, 8 y 9, lo cual es consistente con lo reportado por Li et al. (2020), quienes observaron que esta especie puede crecer en concentraciones de NaCl cercanas al 0% y superiores al 6% y en un rango de pH de 5 a 9, aunque con un crecimiento más lento. Asimis-mo, nuestra cepa mostró actividad antibacteriana y formación de biopelículas, coincidiendo con los hallazgos de Rabbee et al. (2019) y Devi et al. (2019). Por último, se confirmó la inhibición de Vibrio spp., lo que respalda el potencial antimi-crobiano de B. velezensis, con lo documentado por Li et al. (2020).
Los resultados obtenidos para Bacillus lichenifor-mis (Bl) coinciden en gran medida con estudios previos, confirmando su carácter Gram positivo, catalasa y motilidad positivas, capacidad para formar esporas, la hidrolisis positiva de gelatina (Sosa et al., 2011; Vivas et al., 2008). La cepa mostró crecimiento en valores de pH de 6 y 8, pero no a pH 9. Estos resultados coinciden parcialmente con los reportados por Rosabal et al. (2021), quienes mencionan que el crecimiento aumenta con el pH. Sin embargo, en nuestro estudio, el crecimiento se detuvo a pH 9, lo que sugiere una limitación en condiciones más alcalinas. Además, la cepa presentó tolerancia a concentraciones de NaCl de 7% (Sosa et al., 2011; Vivas et al., 2008), y también a 0%, aunque el crecimiento en 0% de NaCl no ha sido reportado previamente. Este crecimiento en ausencia de sal es una observación inesperada, dado que en los manglares la salinidad suele ser alta. Asimismo, se observó formación de biofilm y actividad antimicrobiana contra Vibrios, resultados que coinciden con los hallazgos de Shleeva et al. (2023). Esto refuerza el potencial de la cepa para el control biológico de patógenos en ambientes acuáticos.
Los resultados obtenidos para Bacillus mycoides (Bmy) coinciden con los resultados por Najafi et al. (2010), confirmando que esta bacteria es Gram positiva, catalasa positiva, motilidad positiva y con capacidad para formar esporas e hidrolizar gelatina. Con relación al crecimiento a diferente salinidad, nuestros datos revelan que la bacteria creció en concentración de NaCl del 0%, pero no en 7%. Estos resultados contrastan parcialmente con los hallazgos de Ali et al. (2022), quienes indicaron que B. mycoides puede tolerar y mostrar crecimiento significativo en concentraciones de NaCl del 0% hasta 3%. La ausencia de crecimiento en 7% de NaCl en nuestro estudio podría deberse a que B. mycoides no tolera concentraciones tan altas de sal, lo que es consistente con el rango de tolerancia reportado por Ali et al. (2022). Además, nuestro estudio mostró la formación de biopelículas, lo cual concuerda con los resultados obtenidos por Ali et al. (2022). Y en cuanto a la inhibición de Vibrios, Ambas et al. (2013) indican que esta cepa posee propiedades antibacterianas contra el género Vibrio. Sin embargo, nuestros resultados muestran que B. mycoides no exhibe actividad antibacteriana contra este patógeno, lo que puede deberse a la variabilidad genética que existe en las bacterias.
Los resultados obtenidos para Bacillus amyloli-quefaciens (Ba) son similares con estudios previos. Esta bacteria se presenta como Gram positiva, formadora de esporas, catalasa positiva, motilidad positiva y también presenta la capacidad de hidrolizar gelatina Guillén-Cruz et al. (2006). En nuestros resultados, la bacteria mostró un crecimiento óptimo en pH entre 6, 8 y 9 y en concentraciones de NaCl de 0% y 7%. Estos hallazgos concuerdan con los reportados por Montor-Antonio et al. (2014), quienes observaron un crecimiento en un intervalo de 1-11,5 sugiriendo que la cepa estudiada puede sobrevivir y desarrollarse en un amplio rango de pH. En cuanto al crecimiento en diferentes salinidades se reporta un crecimiento en concentraciones de hasta 7% de NaCl, pero con una rápida disminución del crecimiento después del 3% de NaCl, cuyos datos también se confirman con Afrin & Bhuiyan (2023).Además, esta cepa bacteriana mostró una notable actividad antibacteriana y capacidad para formar biopelículas, lo cual concuerda con los resultados de Ley-López et al. (2021). La capacidad de nuestra cepa para inhibir Vibrio spp. coincide con los resultados reportados por Afrin & Bhuiyan (2023), indicando un amplio espectro de actividad antimicrobiana frente a patógenos del género Vibrio spp. Estos hallazgos resaltan el potencial de esta cepa para aplicaciones en la prevención y control de infecciones asociadas con estos microorganismos patógenos.
Todas las características observadas desempeñan un papel crucial en el ecosistema de manglar. Por ejemplo, la prueba de Shaeffer-Fulton permitió identificar la presencia de esporas en las bacterias aisladas, estas permiten a las cepas dispersarse y sobrevivir en condiciones desfavorables, como la falta de nutrientes o factores climáticos extremos, manteniéndose viables por largos periodos de tiempo (Mawarda et al., 2022). La enzima catalasa, con sus propiedades antioxidantes, protege a las bacterias contra el estrés oxidativo y puede ayudar a las plantas del manglar a tolerar cambios bruscos de salinidad y pH, factores comunes en estos ecosistemas (Saeed et al., 2023). La capacidad de producir proteasas, evidenciada a través de la hidrólisis de gelatina, es crucial para descomponer materia orgánica en los sedimentos, facilitando el reciclaje de nutrientes y fomentando interacciones ecológicas importantes (Afrin et al., 2024). Por su parte, las bacterias que inhiben el crecimiento de Vibrios pueden actuar como controladores biológicos en el manglar, limitando la proliferación de patógenos peligrosos para la fauna acuática y manteniendo el equilibrio del ecosistema (Chen et al., 2024). La capacidad de crecer bajo diferentes niveles de salinidad y pH refleja su adaptación a las condiciones extremas del manglar, permitiéndoles participar en procesos como la descomposición de materia orgánica y la biorremediación de contaminantes. Además, la formación de biopelículas, estructuras extracelulares que protegen a las bacterias de la radiación UV y de la acidez, contribuye a su resistencia frente a las fluctuaciones ambientales, favoreciendo su supervivencia y manteniendo la funcionalidad del ecosistema (Tran et al., 2022).
CONCLUSIONES
Este estudio proporciona avances significativos en la comprensión del género Bacillus en ecosistemas de manglar. Los resultados destacan la adaptabi-lidad de estas bacterias a condiciones ambientales extremas, subrayando la importancia de los manglares como hábitats para microorganismos con potencial biotecnológico. El uso del medio cromogénico ha demostrado ser una herramienta eficaz para la identificación de Bacillus, lo que abre nuevas oportunidades para su aplicación.
Futuras investigaciones podrían centrarse en ampliar el conocimiento sobre la interacción de estas bacterias con su entorno y otros microorganismos, así como explorar su aplicación biotecnológica en diversos sectores productivos, abriendo nuevas posibilidades en el aprove-chamiento de la biodiversidad microbiana de los manglares.












 uBio
uBio